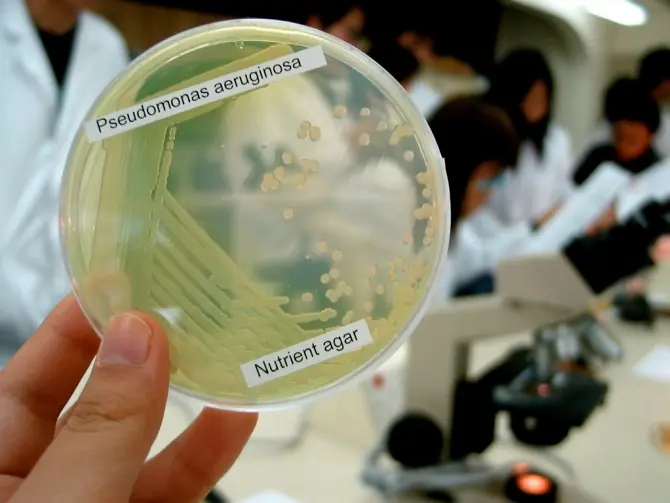
bacterias
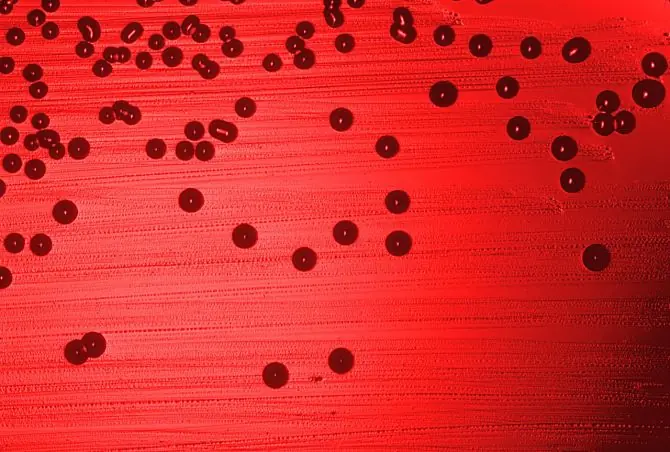
antibioticos
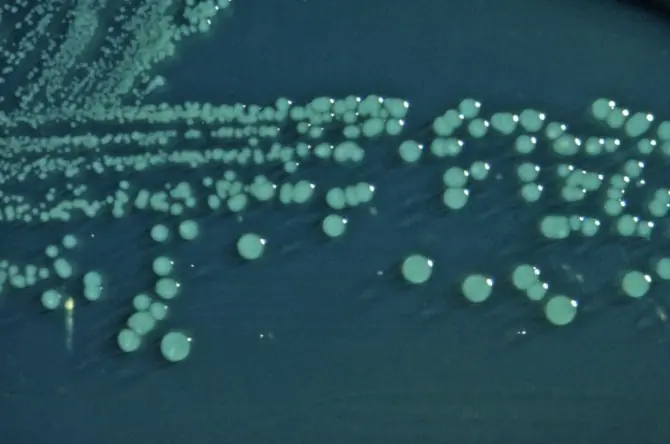
bacterias

La Organización Mundial de la Salud ha elaborado una lista con los doce microorganismos para los que se necesitan medicamentos de forma urgente. Estos patógenos prioritarios son conocidos por haber desarrollado resistencia a los antibióticos, por lo que el catálogo de doce bacterias incluye a los microbios que suponen un auténtico riesgo para la salud pública.
El listado ha sido publicado con el objetivo de promover la investigación y el desarrollo de nuevos fármacos, que puedan hacer frente a las bacterias resistentes a los antibióticos. Según ha explicado la OMS en un comunicado, la resistencia microbiana es un problema creciente contra el que la humanidad se está quedando poco a poco sin terapias eficaces. De ahí la clasificación impulsada por la organización, que divide a los microorganismos en función de si la necesidad de nuevos antibióticos es más o menos urgente.
1. Prioridad crítica
Acinetobacter baumannii
Este microorganismo resistente al fármaco carbapenem es uno de los más peligrosos, según la Organización Mundial de la Salud. Las estimaciones apuntan que la bacteria causa decenas de miles de muertos al año en hospitales de Estados Unidos, al estar detrás de enfermedades como neumonías o infecciones del tracto urinario.
Pseudomonas aeruginosa
Este microbio, resistente al mismo medicamento que Acinetobacter, es un patógeno oportunista que ataca a personas inmunocomprometidas, y es capaz de infectar órganos como los pulmones y las vías respiratorias. Muchos individuos afectados por fibrosis quística terminan falleciendo por culpa de la infección de esta bacteria.
Enterobacter
Al igual que Pseudomonas aeruginosa, este tipo de microorganismos pueden ser patógenos oportunistas, bacterias descomponedoras de la materia orgánica o integrantes de la microbiota normal de los seres humanos. La Organización Mundial de la Salud ha resaltado la necesidad de desarrollar antibióticos contra los microorganismos de este género que sean resistentes al carbapenem.
2. Prioridad alta
Enterococcus faecium
Este microorganismo también puede habitar en el intestino humano sin causar daño, aunque a los especiales les preocupa la especie resistente a vancomicina, que puede provocar enfermedades como la meningitis neonatal.
Este microorganismo también puede habitar en el intestino humano sin causar daño, aunque a los especiales les preocupa la especie resistente a vancomicina, que puede provocar enfermedades como la meningitis neonatal.
Staphylococcus aureus
El estafilococo dorado es un tipo de microbio que tiene gran importancia al estar detrás de las conocidas infecciones nosocomiales. La bacteria se encuentra normalmente en la piel de personas sanas; sin embargo, en el caso de individuos inmunocomprometidos, pueden provocar problemas graves. Preocupa especialmente el microorganismo resistente a antibióticos como la vancomicina y la metilicina.
Helicobacter pylori
El descubrimiento de este microorganismo protagonizó el Premio Nobel de Fisiología o Medicina de 2005. Y es que los microbiólogos responsables del hallazgo comprobaron que muchas de las úlceras de estómago estaban provocados por esta bacteria, con lo que el tratamiento con antibióticos podría curar esta enfermedad. A día de hoy, por desgracia, la OMS resalta la gravedad de los microorganismos de esta especie resistentes al antibiótico claritromicina.
Campylobacter
De un problema digestivo a otro. El género Campylobacter es un ejemplo de bacteria que está detrás de numerosos trastornos intestinales, particularmente diarreas y gastroenteritis. Aunque las infecciones por este microbio suelen ser leves, puede provocar problemas graves en personas inmunocomprometidas y niños. El microorganismo está incluido en este listado por su resistencia a la fluroquinolona.
Salmonella
Salmonella es la bacteria causante de salmonelosis, que con 100.000 casos anuales en Europa genera pérdidas de más de 3.000 millones de euros. El microorganismo, capaz de sacrificar a su descendencia para mantener su ataque infectivo, ha sido identificado en las ensaladas de bolsa que se venden en los supermercados. La OMS lo ha incluido en su listado por ser resistente al antibiótico fluroquinolona, como sucede con Campylobacter.
Neisseria gonorrhoeae
El microbio provoca la enfermedad de transmisión sexual conocida como gonorrea. Esta patología era potencialmente mortal hasta la introducción de los antibióticos, pero la OMS estima que su riesgo ha vuelto a incrementarse por culpa de la resistencia bacteriana, particularmente hacia medicamentos como la fluroquinolona y la cefalosporina.
3. Prioridad media
Streptococcus pneumoniae
Este microorganismo es un patógeno casi exclusivo de los seres humanos, y está detrás de infecciones tan conocidas como la neumonía, la sinusitis y la peritonitis. Debido a que la bacteria ya no responde a la penicilina, la Organización Mundial de la Salud ha decidido incluir al microbio en esta clasificación de patógenos.
Haemophilus influenzae
Este grupo de bacterias, que no está asociada con la gripe, ya que está infección está causada por un virus, es también un problema de salud pública a día de hoy. El microorganismo se relaciona con enfermedades como la neumonía, la sinusitis, la otitis o la meningitis. Preocupa la resistencia observada frente al medicamento llamado ampicilina.
Shigella
La última bacteria en el listado de la Organización Mundial de la Salud es Shigella. Este patógeno provoca una enfermedad denominada disentería, que se caracteriza por síntomas como la diarrea, los vómitos, la fiebre o las naúseas. También se ha relacionado con el desarrollo de enfermedades raras como el síndrome hemolítico urémico. Al igual que otros microbios del listado de la OMS, esta especie ha desarrollado resistencia a la fluoroquinolona.

El listado ha sido publicado con el objetivo de promover la investigación y el desarrollo de nuevos fármacos, que puedan hacer frente a las bacterias resistentes a los antibióticos. Según ha explicado la OMS en un comunicado, la resistencia microbiana es un problema creciente contra el que la humanidad se está quedando poco a poco sin terapias eficaces. De ahí la clasificación impulsada por la organización, que divide a los microorganismos en función de si la necesidad de nuevos antibióticos es más o menos urgente.
1. Prioridad crítica
Acinetobacter baumannii

Este microorganismo resistente al fármaco carbapenem es uno de los más peligrosos, según la Organización Mundial de la Salud. Las estimaciones apuntan que la bacteria causa decenas de miles de muertos al año en hospitales de Estados Unidos, al estar detrás de enfermedades como neumonías o infecciones del tracto urinario.
Pseudomonas aeruginosa
Este microbio, resistente al mismo medicamento que Acinetobacter, es un patógeno oportunista que ataca a personas inmunocomprometidas, y es capaz de infectar órganos como los pulmones y las vías respiratorias. Muchos individuos afectados por fibrosis quística terminan falleciendo por culpa de la infección de esta bacteria.
Enterobacter

Al igual que Pseudomonas aeruginosa, este tipo de microorganismos pueden ser patógenos oportunistas, bacterias descomponedoras de la materia orgánica o integrantes de la microbiota normal de los seres humanos. La Organización Mundial de la Salud ha resaltado la necesidad de desarrollar antibióticos contra los microorganismos de este género que sean resistentes al carbapenem.
2. Prioridad alta
Enterococcus faecium

Este microorganismo también puede habitar en el intestino humano sin causar daño, aunque a los especiales les preocupa la especie resistente a vancomicina, que puede provocar enfermedades como la meningitis neonatal.
Este microorganismo también puede habitar en el intestino humano sin causar daño, aunque a los especiales les preocupa la especie resistente a vancomicina, que puede provocar enfermedades como la meningitis neonatal.
Staphylococcus aureus

El estafilococo dorado es un tipo de microbio que tiene gran importancia al estar detrás de las conocidas infecciones nosocomiales. La bacteria se encuentra normalmente en la piel de personas sanas; sin embargo, en el caso de individuos inmunocomprometidos, pueden provocar problemas graves. Preocupa especialmente el microorganismo resistente a antibióticos como la vancomicina y la metilicina.
Helicobacter pylori

El descubrimiento de este microorganismo protagonizó el Premio Nobel de Fisiología o Medicina de 2005. Y es que los microbiólogos responsables del hallazgo comprobaron que muchas de las úlceras de estómago estaban provocados por esta bacteria, con lo que el tratamiento con antibióticos podría curar esta enfermedad. A día de hoy, por desgracia, la OMS resalta la gravedad de los microorganismos de esta especie resistentes al antibiótico claritromicina.
Campylobacter

De un problema digestivo a otro. El género Campylobacter es un ejemplo de bacteria que está detrás de numerosos trastornos intestinales, particularmente diarreas y gastroenteritis. Aunque las infecciones por este microbio suelen ser leves, puede provocar problemas graves en personas inmunocomprometidas y niños. El microorganismo está incluido en este listado por su resistencia a la fluroquinolona.
Salmonella

Salmonella es la bacteria causante de salmonelosis, que con 100.000 casos anuales en Europa genera pérdidas de más de 3.000 millones de euros. El microorganismo, capaz de sacrificar a su descendencia para mantener su ataque infectivo, ha sido identificado en las ensaladas de bolsa que se venden en los supermercados. La OMS lo ha incluido en su listado por ser resistente al antibiótico fluroquinolona, como sucede con Campylobacter.
Neisseria gonorrhoeae

El microbio provoca la enfermedad de transmisión sexual conocida como gonorrea. Esta patología era potencialmente mortal hasta la introducción de los antibióticos, pero la OMS estima que su riesgo ha vuelto a incrementarse por culpa de la resistencia bacteriana, particularmente hacia medicamentos como la fluroquinolona y la cefalosporina.
3. Prioridad media
Streptococcus pneumoniae

Este microorganismo es un patógeno casi exclusivo de los seres humanos, y está detrás de infecciones tan conocidas como la neumonía, la sinusitis y la peritonitis. Debido a que la bacteria ya no responde a la penicilina, la Organización Mundial de la Salud ha decidido incluir al microbio en esta clasificación de patógenos.
Haemophilus influenzae
Este grupo de bacterias, que no está asociada con la gripe, ya que está infección está causada por un virus, es también un problema de salud pública a día de hoy. El microorganismo se relaciona con enfermedades como la neumonía, la sinusitis, la otitis o la meningitis. Preocupa la resistencia observada frente al medicamento llamado ampicilina.
Shigella
La última bacteria en el listado de la Organización Mundial de la Salud es Shigella. Este patógeno provoca una enfermedad denominada disentería, que se caracteriza por síntomas como la diarrea, los vómitos, la fiebre o las naúseas. También se ha relacionado con el desarrollo de enfermedades raras como el síndrome hemolítico urémico. Al igual que otros microbios del listado de la OMS, esta especie ha desarrollado resistencia a la fluoroquinolona.


